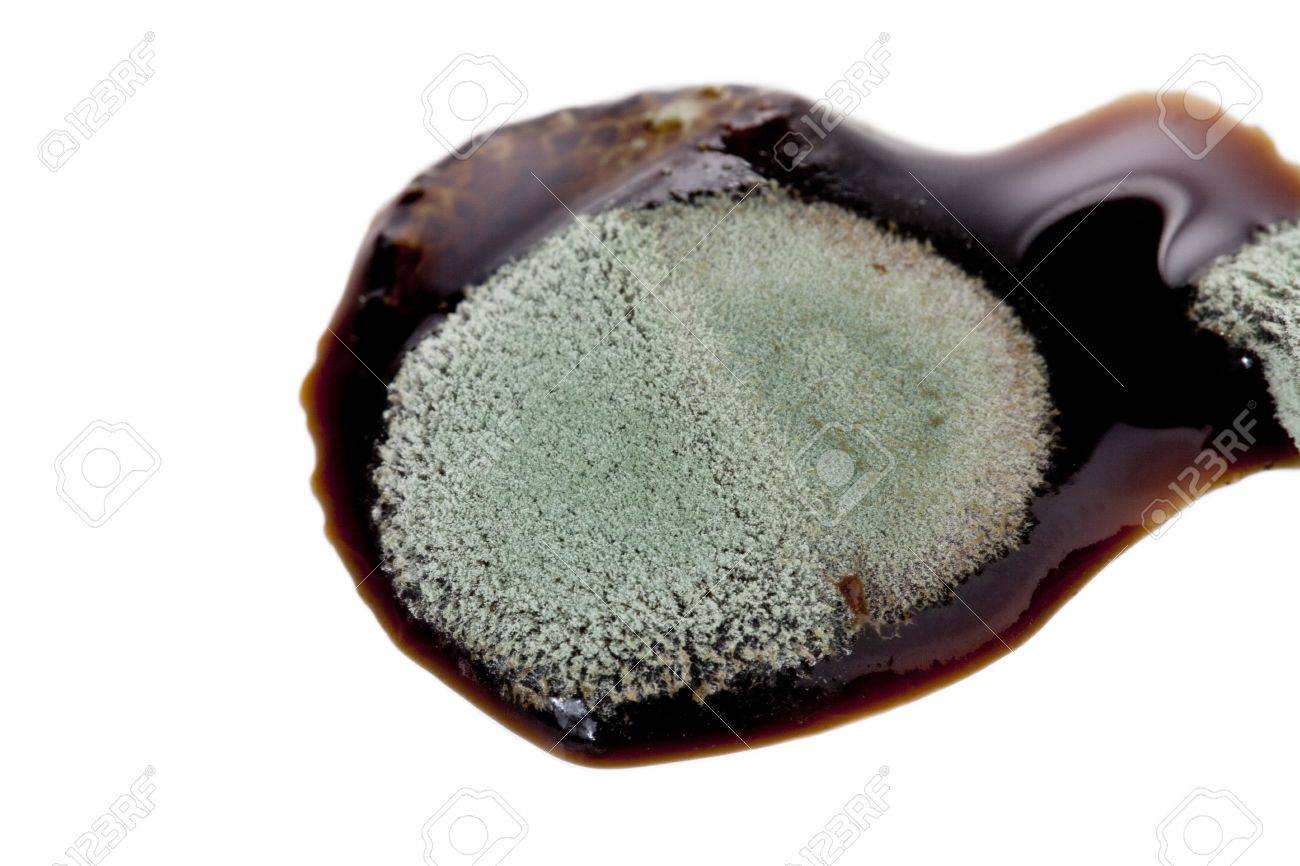
Can brown sugar mold

The sugar granules just look. Can brown sugar mold.

If you suspect mold to be in your brown sugar and if it smells moldy just throw it away.
Can brown sugar mold. In fact this sugar is kind of moist sticky and clumped together to begin with. You can see parts which have clumps of molasses in them. This is not like your processed brown sugar you get in little.
Can brown sugar mold. In general molds dont grow on sugar because this type of food is anti-microbial and is a type of preservative in itself. However since brown sugar has a moist texture its not impossible for mold to grow on it.
However since brown sugar has a moist texture its not impossible for mold to grow on it. This rarely happens but when brown sugar is exposed to humid temperature mold can indeed grow. If you suspect mold to be in your brown sugar and if it smells moldy just throw it away.
Brown sugar is white sugar with molasses added. I guess depends on conditions. Air tight I dont think it would mold what mold lives in an oxygenlight deficient atmosphere.
Are there any anaerobic molds. All you need is some brown sugar. You can use any object to make a chocolate mold.
After making the shape you prefer pour the melted chocolate and let it si. I noticed some white regions in my dark brown sugar. It doesnt look like mold or a foreign substance.
The sugar granules just look. Very very light colored. Id like to take a high-res pic to show but I cant find a good camera.
I didnt think mold could grow in sugar because of the moisture absorption. Firearm Discussion and Resources from AR-15 AK-47 Handguns and more. Buy Sell and Trade your Firearms and Gear.
While brown sugar definitely can go bad in almost all cases yours will be fine and safe to use. If you would like to learn a little about storing brown sugar its shelf life and how to tell if its off read along. How To Tell If Brown Sugar Is Bad.
Discard your brown sugar if. Youve found any dead or alive bugs in it. There are any other contaminants in the package.
You see any signs of mold. 8 Can Brown Sugar grow mold. 9 How do you make brown sugar without molasses.
10 Is brown sugar and shakkar same. 11 Is brown sugar healthy. How do you make homemade brown sugar.
How to Make Brown Sugar. You may ask How much molasses is in brown sugar. For each cup of sugar add 1 to 2 tablespoons of molasses for light brown sugar and up to 14 cup for dark brown sugar.
Sugar molds generally take the form of a long solid block with a series of depressions into which raw sugar cane syrup could be poured. Once it dried the syrup formed raw brown sugar cones which was how sugar was once sold to consumers. The cones were easy to transport and store and more refined sugar processing methods had not yet been developed.
8 Does brown sugar mold. 9 How do you know when brown sugar goes bad. 10 Why does my brown sugar get so hard.
11 How do you keep brown sugar soft and fresh. How do you Unclump brown sugar. Place the dried-out brown sugar in a microwave-safe bowl and top with a slice of fresh bread or a damp paper towel.
Cover the bowl with plastic wrap and microwave it in 15-second intervals until the sugar is. But I have a mad genius tip for using brown sugar to mold chocolate. So youre going to spread an even layer of brown sugar all over the baking sheet.
And once you have it in a nice even layer. Check out our brown sugar mold selection for the very best in unique or custom handmade pieces from our shops. Brown sugar is the perfect medium for casting poured chocolate in a homemade mold.
This simple project will set your imagination wild. Click here to see the results of Chocolate Casting. Part II where I experiment with other casting mediums.
If youre looking for a unique gift or just another way to keep your chocolate addiction going you can cast chocolate into custom shapes using a mold made from brown sugar. Why does brown sugar harden. This can be partly attributed to moisture in the sugar.
When moisture evaporates the brown sugar clumps together. Yet this isnt that a bad of a problem because you can always re-shape it after it has hardened. Proper ways of storing brown sugar.
A jar of Brown Sugar and Brown Sugar on the table. While brown sugar doesnt go bad it doesnt mean that you. Can brown sugar mold.
However since brown sugar has a moist texture its not impossible for mold to grow on it. This rarely happens but when brown sugar is exposed to humid temperature mold can indeed grow. If you suspect mold to be in your brown sugar and if it smells moldy just throw it away.
What is a brown sugar saver. Soften rock hard brown sugar with this.